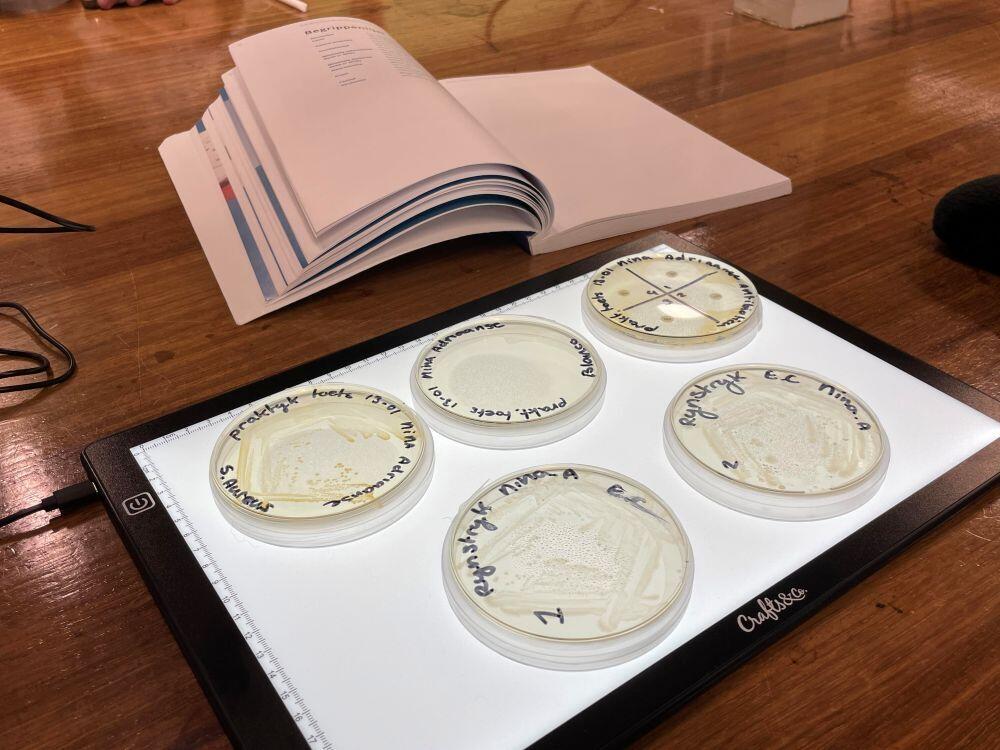
Vijf petrischaaltjes met bacteriën liggen op een tafel

Iets voor jou?
Weten waar drinkwater of tapijt uit bestaat? Onderzoek het! Lees hier alles over de mbo-opleiding Allround laborant van Aventus in Deventer.
- Opleidingscode
- 25951
- Niveau
- Niveau 3
- Richting
- Laboratorium
- Opleidingsduur
- 2,5 jaar
- Kosten
- € 1.458,- lesgeld per jaar (vanaf 18 jaar).
-
Startdatum
Bij deze opleiding kun je eventueel tussentijds starten. Na je aanmelding overleggen we met je of dit in jouw situatie lukt.
- Augustus 2026
- Tussentijds starten (in overleg)
Magazine aanvragen?
Lees onze tips over het kiezen van een mbo-opleiding.

Inloopavond | Apeldoorn
Kom dinsdag 23 juni naar de inloopavond in Apeldoorn, speciaal voor geïnteresseerden in mbo en ook de vavo.
Zien we je daar?

Wat leer je
Wat wordt je beroep
Belangrijk om te weten
Extra kosten
Gerelateerde opleidingen
Chemisch-fysisch analist (BOL)

Biologisch medisch analist (BOL)

Verdieping hematologie | K0645